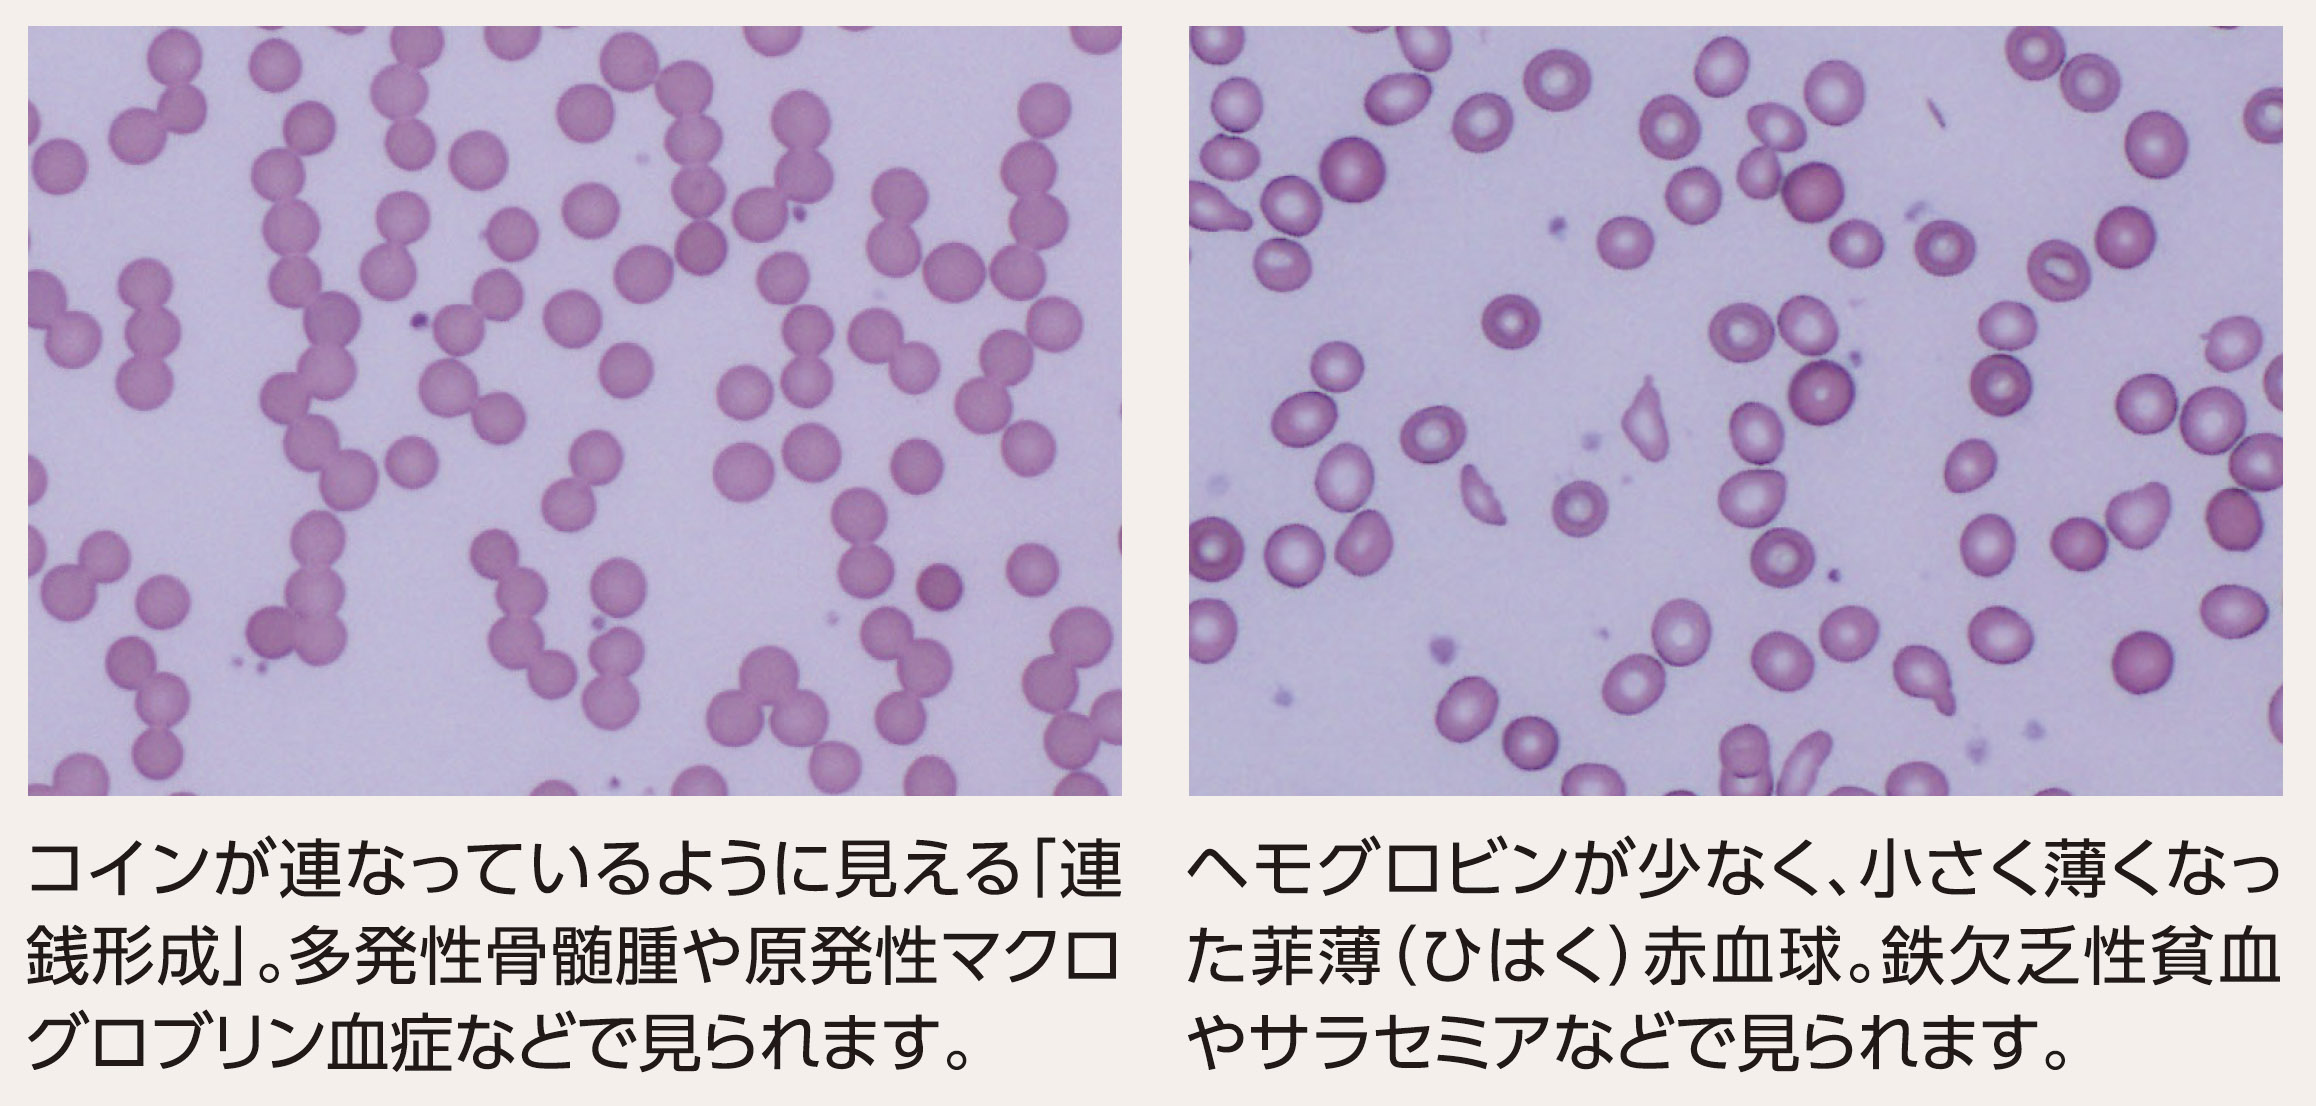

血液について
人間の血液の量は体重の約8%で、体重50キログラムの人であれば約4リットルの血液が体内を流れていることになります。血液は「赤血球」「白血球」「血小板」の血球と、「血漿(けっしょう)」という液体で構成され、それぞれが大切な役割を担っています。このうち貧血に関係するのは主に赤血球です。

貧血の概要
貧血とは、血液中の赤血球に含まれるヘモグロビンが減ることによって、体に充分な酸素が行き届いていない状態を指します。貧血の主な自覚症状は動悸、息切れ、めまい、頭痛、頻脈、頻呼吸、疲れやすいなど様々ですが、実は自覚症状がないまま貧血になっている方は多くいます。
逆に、急に立ち上がった時に視界が暗くなったりする一時的な立ちくらみは、脳への血流が低下することによるもので、すなわち貧血であるというわけではありません。
貧血になる原因は様々で、中には重篤な疾患が隠れていることもあるため、軽く考えないようにすることが必要です。貧血であるかないかは血液検査ですぐにわかりますので、日頃から健康診断を積極的に受診し、ご自身の状態を把握しておきましょう。

貧血の検査と原因について
「貧血の検査」
貧血かどうかの判別
貧血であるかどうかは、血液検査でヘモグロビン値を調べることで判別します。その基準はWHO(世界保健機関)によって以下のように定められています。

MCV(平均赤血球容積)検査
ヘモグロビンの値で貧血が疑われた場合、次にどういったタイプの貧血かを調べるためにMCV(平均赤血球容積)検査を行います。MCV検査はわかりやすく言うと赤血球の大きさを調べるもので、これによって大まかに以下の3つのタイプに分類することができます。

顕微鏡検査
赤血球そのものを顕微鏡で観察することで得られる情報も多くあります。医師と臨床検査技師との連携が重要になる検査です。
「貧血の原因」
貧血の原因は非常に多くの可能性が考えられ、さらにそれらが複合的に重なっている場合もあります。したがって、診断においては検査結果だけでなく、患者さんの年齢や性別、全身の健康状態、生活習慣などの情報を基に総合的に究明していく必要があります。
栄養不足よる貧血
鉄やビタミン類、微量元素(銅や亜鉛等)が不足することで起きる貧血です。最も多いのは鉄欠乏性貧血で、女性であれば生理の影響や子宮筋腫、それ以外だと消化管からの出血も疑われます。特に消化管からの出血は胃や腸のがんも考えられるため、速やかに内視鏡による検査が必要となります。
ビタミン類は血液を作る際や鉄分を吸収する際に必要な栄養素。またアルコールの摂り過ぎや無理なダイエットも栄養不足に繋がることがあります。
慢性疾患による貧血
うっ血性心不全、腎不全、悪性腫瘍、自己免疫疾患、内分泌疾患、感染症などの慢性疾患も貧血の原因となります。貧血の約1/3は慢性疾患によって引き起こされます。
血液の病気
貧血と聞くと最初に想像するのが血液の病気かもしれません。多発性骨髄腫、再生不良性貧血、白血病などが挙げられます。専門的な治療が必要になりますが、割合としてはそう多くはありません。
高齢者の貧血
高齢になると体の中で血液を作る能力が落ちてくるため、貧血になりやすくなってきます。高齢者の貧血の原因としては上記に加え、加齢によるものが増えますが、原因が不明な場合も1/3ほどあります。
注意しなければならないのは血液のがんである多発性骨髄腫で、加齢にしたがって罹患率が上がります。症状がないまま進行することが多く、進行すると貧血だけでなく体中の骨が折れやすくなるなどの症状が表れます。
高齢の患者さんの貧血については特に注意深く鑑別を行う必要があります。
「広島共立病院 糖尿病内科の特徴」
血液専門医は数が多くなく、血液を専門で診療ができる医療機関は限られます。広島共立病院の血液内科は2025年5月に診療を始めたばかりですが、血液専門医の知見を活かし、血液に関する様々な疾患に対する相談窓口として地域に貢献しています。
また、院内で別の科を受診されている患者さんについても、他に疾患が隠れていないかを血液検査の際に臨床検査技師が慎重にチェックするなど、多職種が一丸となって体制をさらに充実させていきます。
血液の病気は自覚症状のないことも多く、軽く考えてしまいがちですが、時には生命におよぶ疾患が潜んでいることもあります。健康診断で貧血を指摘されたことのある方は、症状の有無にかかわらず一度受診をお勧めします。専門医が様々な可能性を想定しながら診断していきますので、わからないことはなんでもご相談ください。
